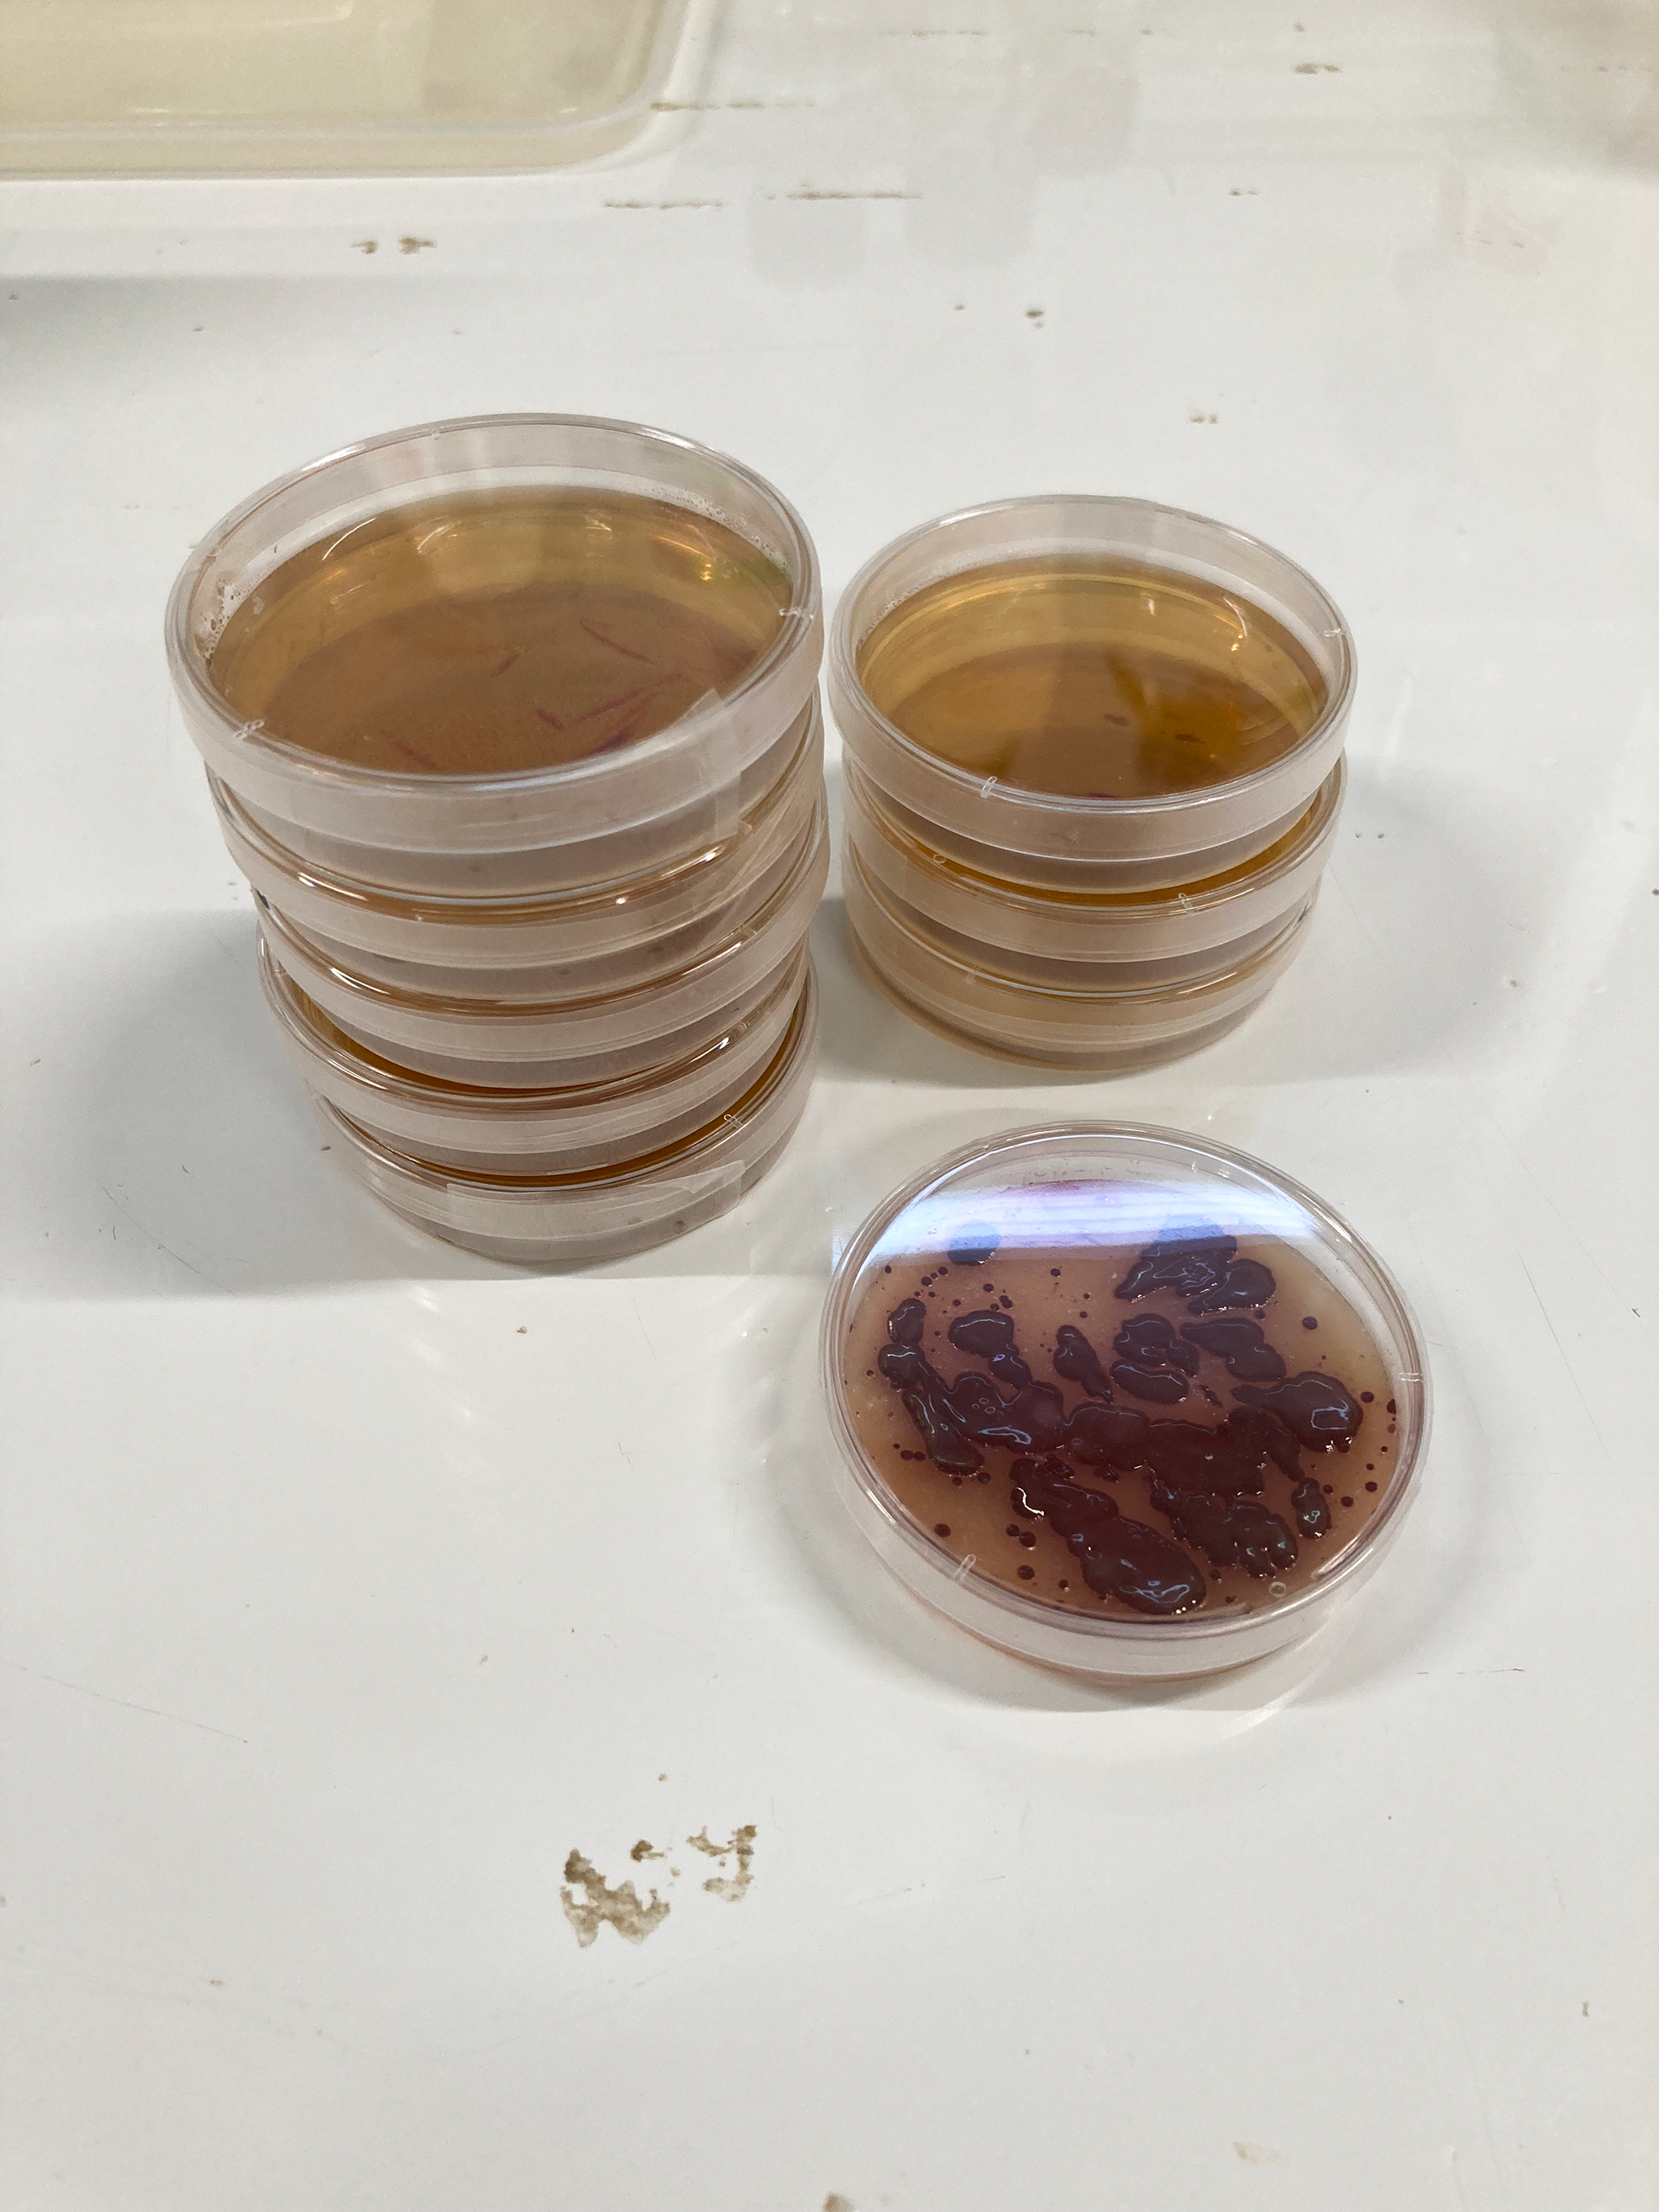

THIS PROJECT EXPLORES THE RELATIONSHIP BETWEEN MEDIUM AND THE DYEING BACTERIA 'JANTHINOBACTERIUM LIVIDUM' THROUGH COLOUR ANALYSIS OF BACTERIAL INTERACTION AND CULTIVATION IN DIFFERENT ENVIRONMENTS. THE EXPERIMENTS BRING SMALL, IN-VITRO LABORATORY SAMPLES TO IN-VIVO, FULL FASHION-SCALE PROTOTYPES, BRIEFLY ADDRESSING THE IMPACT OF SCALE IN WORKING WITH MICROBES.





Mobilis in Mobilis first speculates with the density and nutrient composition of the growth medium of JL as a means to device design tools that enable collaboration with the non-human. The workshop approach proposed by FabCafe Kyoto encourages the use of low-tech settings and methodologies, as well as sharing progress and collaboration with the other participants. Therefore, Mobilis in Mobili adopts these principles as core to the concept, and focuses on the question;
「 HOW DOES THE GROWTH MEDIUM AFFECT THE COLOUR RESULTS FROM JANTHINOBACTERIUM LIVIDUM? 」
The design variables iterate medium density and nutrient composition before introducing cellulose in the form of powder, fabric and pellicle . Finally, these results are scaled up in an attempt to dye a series of second hand garments composed by different fibres.

Ruffled cotton jumper, folded, doused with agar on ruffled areas and inoculated with Janthinobacterium Lividum











Credit @FabCafe Kyoto

Credit @FabCafe Kyoto











"LIVING DYES" Study exhibition of joint bacterial staining research
FabCafe Kyoto Exhibition 11.7 - 11.22 (2023)
Click HERE to explore the event
EXPERIMENTS IN CULTIVATING COLOUR| Living Dyes: Sharing Session
FabCafe Tokyo Exhibition 11.30 - 12.6 (2023)
Click HERE to explore the event
